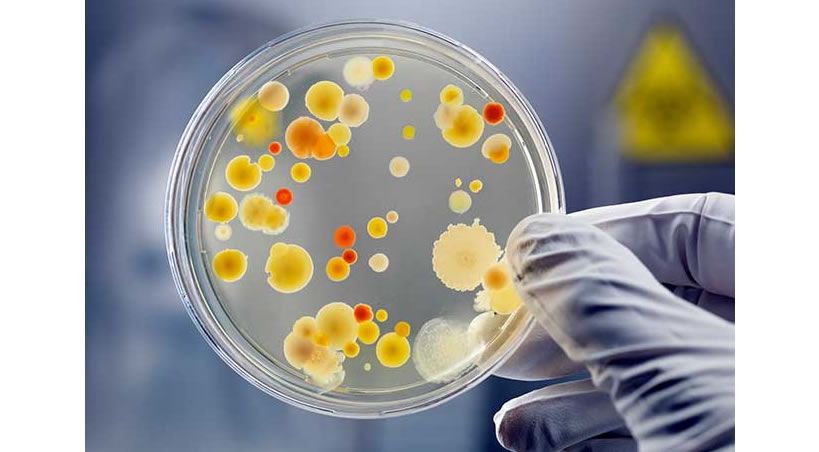

General
Amazon ofrece centenar de audiolibros gratis durante aislamiento por coronavirus
Para acceder a la plataforma Audible, solo es a través de un navegador web y no requiere inresar ninguna tarjeta de crédito o datos personales.
General
La lucha por la supervivencia: fabricantes
Las gafas de realidad aumentada ayudan a los odontólogos aumentando sus índices de seguridad y eficacia, y reduciendo la ansiedad en sus pacientes.
General
Superficie bioactiva que protege contra la caries
Un nuevo recubrimiento protege de la desmineralización. (Imagen: Coffeemill/Shutterstock)
General